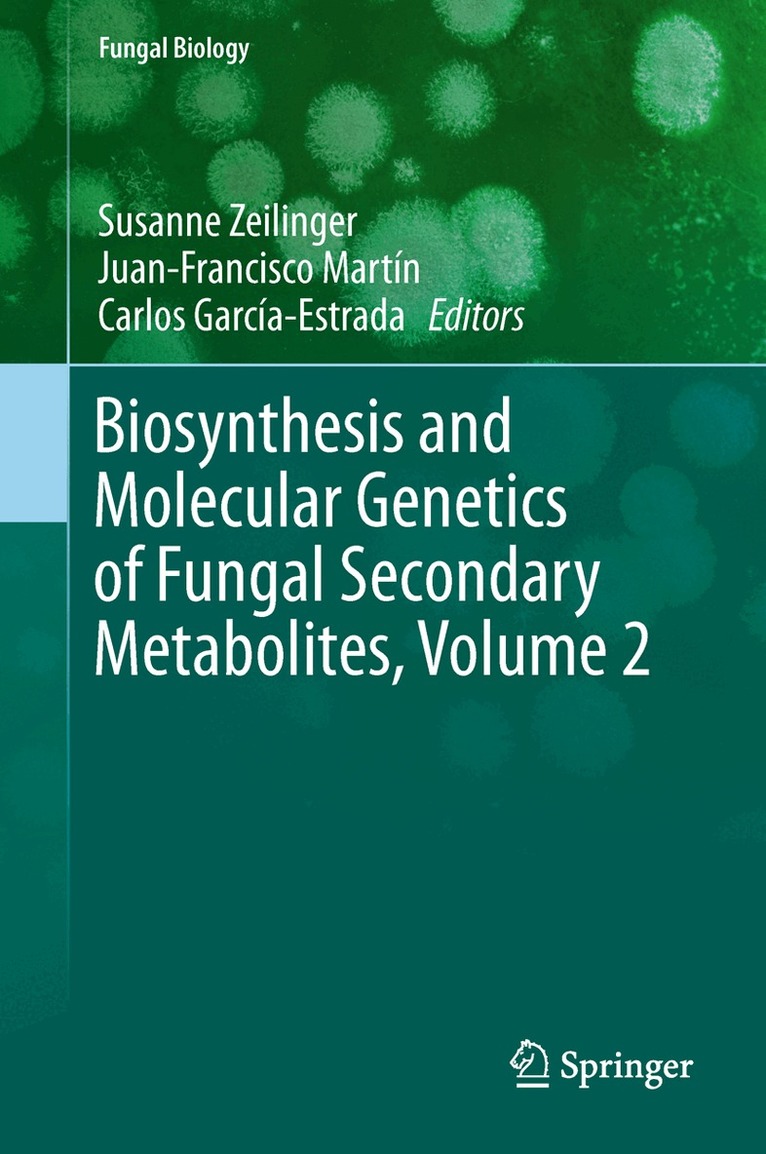
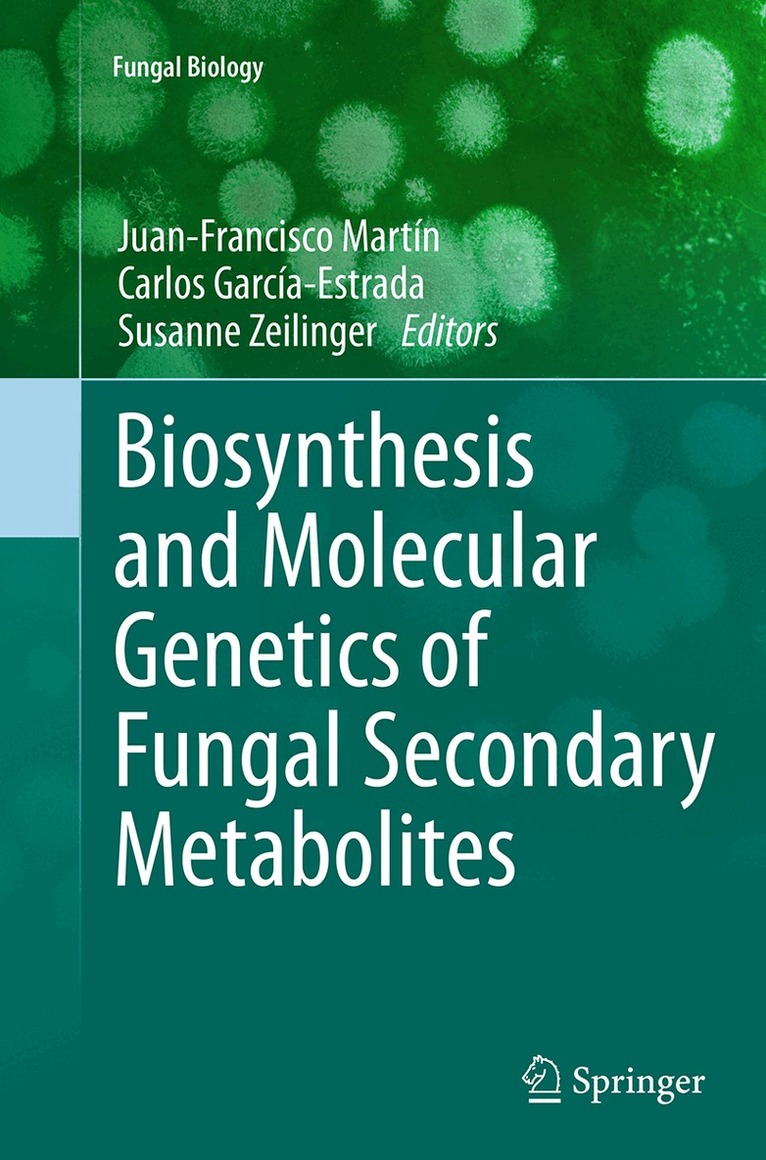

Susanne Zeilinger – författare
2 171 kr
Skickas inom 10-15 vardagar
New and Future Developments in Microbial Biotechnology and Bioengineering: Recent Developments in Trichoderma Research covers topics on-Trichoderma biodiversity, strain improvement and related researches in bioprocess technology, chemical engineering, bioremediation process, secondary metabolite production, Protein production, plant disease resistance and biocontrol technology. This book includes unique compilations of different chapters with emerging issues in the area of Trichoderma research and its related importance in the Biochemical-Industry-Agri-Food sector.
Includes recent developments on Trichoderma research in plant biotechnology, agriculture and in the environment Provides a detailed and comprehensive coverage of the biodiversity and biochemistry of Trichoderma Covers potential applications of Trichoderma in biotechnology, including secondary metabolites and protein engineering3 092 kr
Läs direkt efter köp
1 619 kr
Skickas inom 10-15 vardagar
1 977 kr
Läs direkt efter köp
This volume describes the more relevant secondary metabolites of different fungi with current information on their biosynthesis and molecular genetics. Bolstered with color illustrations and photographs, the book describes the possible application of molecular genetics to directed strain improvement in great detail. The needs for future developments in this field are also discussed at length
Written by authorities in the field, Biosynthesis and Molecular Genetics of Fungal Secondary Metabolites provides a cutting-edge perspective on fungal secondary metabolism and underlying genetics and is a valuable resource for scientists, researchers, and educators in the field of fungal biology.
1 082 kr
Skickas inom 10-15 vardagar
1 367 kr
Läs direkt efter köp
1 619 kr
Skickas inom 10-15 vardagar
1 082 kr
Skickas inom 10-15 vardagar
1 953 kr
Skickas inom 5-8 vardagar
2 217 kr
Läs direkt efter köp
Microbial applications encompass areas including biotechnology, chemical engineering, and alternative fuel development. Research on their technological developments cover many aspects of work using microbes as cell factories. The fields of biotechnology, chemical engineering, pharmaceuticals, diagnostics and medical device development also employ these microbial products. There is an urgent need to integrate all these disciplines that caters to the need of all those who are interested to work in the area of microbial technologies.
This book is a step forward to integrate the aforesaid frontline branches into an interdisciplinary research work quenching the academic as well as research thirst of all those concerned about microbes in the respective area of biotechnology, chemical engineering, and pharmaceuticals. All the chapters in this book are related to important research on microbial applications, written by international specialists for researchers and academics in the concerned disciplines.
This publication aims to provide a detailed compendium of experimental work and information used to investigate different aspects of microbial technologies, their products as well as interdisciplinary interactions including biochemistry of metabolites, in a manner that reflects the recent developments of relevance to researchers/scientists investigating microbes.
2 198 kr
Läs direkt efter köp
Microbial applications encompass areas including biotechnology, chemical engineering, and alternative fuel development. Research on their technological developments cover many aspects of work using microbes as cell factories. The fields of biotechnology, chemical engineering, pharmaceuticals, diagnostics and medical device development also employ these microbial products. There is an urgent need to integrate all these disciplines that caters to the need of all those who are interested to work in the area of microbial technologies.
This book is a step forward to integrate the aforesaid frontline branches into an interdisciplinary research work quenching the academic as well as research thirst of all those concerned about microbes in the respective area of biotechnology, chemical engineering, and pharmaceuticals. All the chapters in this book are related to important research on microbial applications, written by international specialists for researchers and academics in the concerned disciplines.
This publication aims to provide a detailed compendium of experimental work and information used to investigate different aspects of microbial technologies, their products as well as interdisciplinary interactions including biochemistry of metabolites, in a manner that reflects the recent developments of relevance to researchers/scientists investigating microbes.